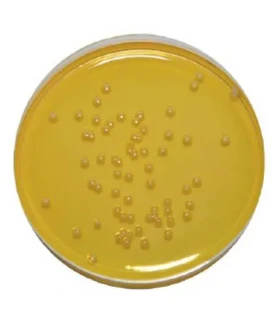
Petritest na opredelenie Stafilokokka

Bosh sahifa / Tibbiy mahsulotlar / Tibbiy anjomlar va sarf materiallari / Ekspress-testlar / #181.Eko-ekspress GIMS Mini-ekspress-laboratoriya
#181.Eko-ekspress GIMS Mini-ekspress-laboratoriya
AsosiyO‘xshash takliflarBoshqa korxonalardan o'xshash takliflarKo‘rilgan mahsulotlarFikr-mulohazalar

Mahsulotning ko'rinishi saytdagi rasmdan farq qilishi mumkin
Mahsulot haqida tafsilotlar
Kategoriya:Ekspress-testlar
Bor
10 000 so'm / dona
U VENDOR OOOdan o'xshash takliflar
Boshqa korxonalardan o'xshash takliflar
Ko‘rilgan mahsulotlar
Fikr-mulohazalar
Reyting 0, 0 ta sharh asosida